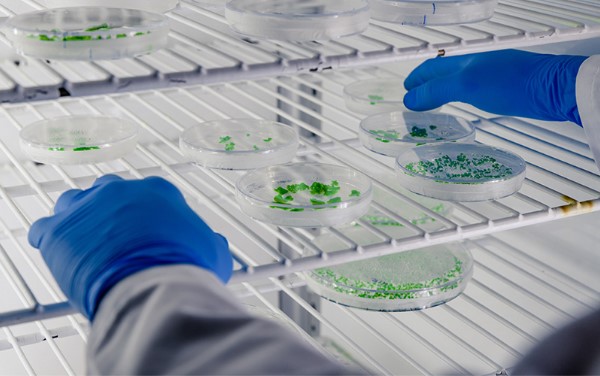

In the realm of scientific research and healthcare innovation, precision and control are crucial. At the heart of many biological experiments and clinical processes lies the laboratory incubator, a specialised device designed to create stable environmental conditions for the growth and maintenance of microbiological cultures or cell lines. In Singapore, where research institutions and biomedical firms are constantly pushing the boundaries of science, the role of such incubators has become increasingly essential.
A laboratory incubator is more than just a heating device. It maintains consistent temperature, humidity, and gas concentration—typically carbon dioxide—to mimic optimal biological conditions. Whether used in a medical laboratory, a university setting, or a pharmaceutical production facility, the incubator enables researchers to replicate conditions similar to those in living organisms. This capability supports critical work in microbiology, tissue engineering, IVF procedures, and pharmaceutical testing.
How Laboratory Incubators Work
The primary function of a laboratory incubator is to provide a controlled environment that supports the development of organisms or cell cultures. It works by regulating heat, and in many cases, moisture and gas levels. These conditions are maintained through precision sensors and internal heating systems, all housed within insulated chambers to ensure stability.
Incubators used in laboratories are typically classified into different types based on their functions and capabilities. These include standard incubators, CO₂ incubators, and shaker incubators. Each serves a specific purpose depending on the experimental requirements. For instance, CO₂ incubators are vital in cell culture applications where pH balance is sensitive to atmospheric changes.
In Singapore’s research landscape, maintaining quality and accuracy is non-negotiable. A malfunctioning incubator could lead to compromised results, affecting entire research cycles. Therefore, regular calibration and preventive maintenance are standard procedures across laboratories nationwide.
Laboratory Ovens Versus Incubators
Although both laboratory ovens and incubators serve the purpose of heating, they are built for very different applications. A laboratory oven is primarily used for drying, sterilising, and heat-treating samples. It operates at much higher temperatures than an incubator and is designed to remove moisture rather than preserve it.
In microbiological or pharmaceutical settings, using the correct equipment is crucial. While a laboratory oven can reach temperatures upwards of 300°C, an incubator generally operates between 5°C above ambient temperature and 60°C, which is ideal for sustaining biological activity. Understanding this difference allows researchers to make informed choices based on their experimental needs.
In a country like Singapore, where space is at a premium, having clearly defined roles for lab equipment ensures efficient use of resources and reduces the risk of equipment misuse. Laboratories in hospitals, biotech firms, and academic settings are increasingly prioritising energy-efficient and space-saving models that serve specific, well-defined functions.
Applications Across Industries
The versatility of a laboratory incubator allows it to be employed across multiple fields. In clinical laboratories, it plays a central role in incubating samples for diagnostic purposes, such as growing bacterial cultures to identify infections. In academic research, it is essential for molecular biology experiments, including gene expression studies and drug efficacy testing.
Singapore’s growing focus on life sciences and biomedical R&D has increased the demand for high-performance laboratory equipment. Incubators, as critical pieces of this ecosystem, are evolving to include features such as remote monitoring, digital temperature control, and automated alerts for environmental changes.
Additionally, in sectors like food and environmental testing, incubators are used to analyse microbial activity in samples to ensure compliance with health standards. This is especially relevant in Singapore, where strict regulatory controls are placed on food safety and environmental sustainability.
Ensuring Quality and Consistency
Maintaining quality within any laboratory setting means investing in reliable, high-precision equipment. While incubators are integral for biological preservation, other lab tools such as a laboratory oven are equally important for ensuring sterility and preparing materials for analysis. Ensuring each device is used in its proper context is essential to preserve the integrity of experimental results.
Laboratories in Singapore often operate under ISO standards, making regular audits and documentation a part of their operational routine. Choosing equipment that meets these international benchmarks adds another layer of assurance to the accuracy and repeatability of results.
Conclusion
Laboratory incubators are not merely storage units—they are scientifically engineered systems that provide the foundation for biological discovery and innovation. From academic research to pharmaceutical development, these devices are at the heart of countless scientific breakthroughs. Understanding their function and differentiating them from other laboratory equipment, such as a laboratory oven, helps create a safer, more efficient environment for experimentation and growth.
If you’re looking to upgrade or understand more about the right lab equipment for your needs, contact Dou Yee today to speak with a specialist who can guide you through the best options available.